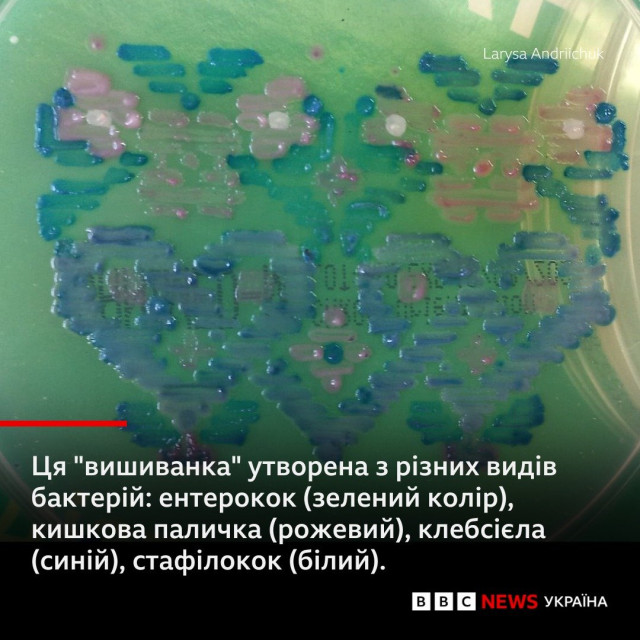

Вишивка бактеріями: мікробіологиня з Волині перемогла у Всеукраїнському конкурсі

Вишивка бактеріями перемогла у Всеукраїнському конкурсі мікробіологів, який щороку організовує громадська організація «Школа клінічного мікробіолога».
Про це пише ВВС.
Її авторка – Руслана Таранюк, яка є керує відділенням клінічної мікробіології Волинського обласного дитячого територіального медичного об’єднання захисту материнства і дитинства.
«Вишиванка для України – це наш культурний код, і цього разу у мене виникла ідея на конкурс малюнку зробити вишивку бактеріями на хромогенному середовищі», – розповіла пані Руслана виданню «Район. Медицина».Читати ще: Волинські лікарі випробували пристрій, що визначає доцільність стентування судин. Відео
Хромогенне середовище – це живильне середовище для ідентифікації різних груп мікроорганізмів, щоби потім призначити правильне лікування.«У нашій роботі найчастіше використовуємо хромогенне середовище для визначення стрептококів групи В, а саме Streptococcus agalactiae. Цей збудник дуже небезпечний для новонароджених, оскільки провокує хвороби, що загрожують життю маленьких пацієнтів», – пояснює мікробіологиня.Всеукраїнський конкурс мікробіологів проводять щороку у вересні. Він присвячений Міжнародному дню мікроорганізмів, який відзначають 17 вересня. Саме цього дня 1683 року голландський натураліст Антоні ван Левенгук вперше побачив мікроорганізм у мікроскоп.
Підписуйтесь на наш Telegram-канал, аби першими дізнаватись найактуальніші новини Волині, України та світу
Про це пише ВВС.
Її авторка – Руслана Таранюк, яка є керує відділенням клінічної мікробіології Волинського обласного дитячого територіального медичного об’єднання захисту материнства і дитинства.
«Вишиванка для України – це наш культурний код, і цього разу у мене виникла ідея на конкурс малюнку зробити вишивку бактеріями на хромогенному середовищі», – розповіла пані Руслана виданню «Район. Медицина».Читати ще: Волинські лікарі випробували пристрій, що визначає доцільність стентування судин. Відео
Хромогенне середовище – це живильне середовище для ідентифікації різних груп мікроорганізмів, щоби потім призначити правильне лікування.«У нашій роботі найчастіше використовуємо хромогенне середовище для визначення стрептококів групи В, а саме Streptococcus agalactiae. Цей збудник дуже небезпечний для новонароджених, оскільки провокує хвороби, що загрожують життю маленьких пацієнтів», – пояснює мікробіологиня.Всеукраїнський конкурс мікробіологів проводять щороку у вересні. Він присвячений Міжнародному дню мікроорганізмів, який відзначають 17 вересня. Саме цього дня 1683 року голландський натураліст Антоні ван Левенгук вперше побачив мікроорганізм у мікроскоп.
Знайшли помилку? Виділіть текст і натисніть
Підписуйтесь на наш Telegram-канал, аби першими дізнаватись найактуальніші новини Волині, України та світу

Коментарів: 0
На Запоріжжі загинув воїн з Волині Сергій Шуляр
Сьогодні 19:14
Сьогодні 19:14
Лісовий пояснив, чому НМТ не планують робити легшим
Сьогодні 18:46
Сьогодні 18:46
Небезпечно для життя: лікарка з Луцька розповіла, коли при тепловому ударі варто викликати швидку
Сьогодні 17:48
Сьогодні 17:48
Росія втрачає головну перевагу у війні, – ЗМІ
Сьогодні 17:19
Сьогодні 17:19

.png)

.jpg)






















Додати коментар:
УВАГА! Користувач www.volynnews.com має розуміти, що коментування на сайті створені аж ніяк не для політичного піару чи антипіару, зведення особистих рахунків, комерційної реклами, образ, безпідставних звинувачень та інших некоректних і негідних речей. Утім коментарі – це не редакційні матеріали, не мають попередньої модерації, суб’єктивні повідомлення і можуть містити недостовірну інформацію.